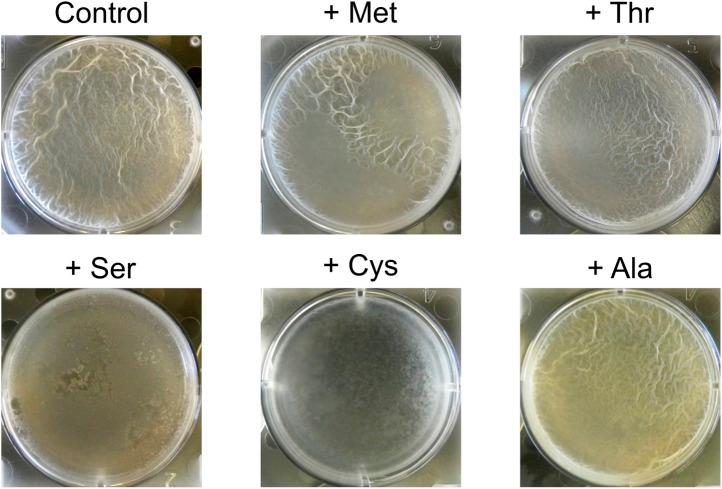
https://cdn.ncbi.nlm.nih.gov/pmc/blobs/189c/3862929/8d903f3becec/elife01501fs006.jpg

一种细菌中用于多细胞性的丝氨酸传感器。
A serine sensor for multicellularity in a bacterium.
作者信息
Subramaniam Arvind R, Deloughery Aaron, Bradshaw Niels, Chen Yun, O'Shea Erin, Losick Richard, Chai Yunrong
机构信息
Department of Molecular and Cellular Biology, Harvard University, Cambridge, United States.
出版信息
Elife. 2013 Dec 17;2:e01501. doi: 10.7554/eLife.01501.
We report the discovery of a simple environmental sensing mechanism for biofilm formation in the bacterium Bacillus subtilis that operates without the involvement of a dedicated RNA or protein. Certain serine codons, the four TCN codons, in the gene for the biofilm repressor SinR caused a lowering of SinR levels under biofilm-inducing conditions. Synonymous substitutions of these TCN codons with AGC or AGT impaired biofilm formation and gene expression. Conversely, switching AGC or AGT to TCN codons upregulated biofilm formation. Genome-wide ribosome profiling showed that ribosome density was higher at UCN codons than at AGC or AGU during biofilm formation. Serine starvation recapitulated the effect of biofilm-inducing conditions on ribosome occupancy and SinR production. As serine is one of the first amino acids to be exhausted at the end of exponential phase growth, reduced translation speed at serine codons may be exploited by other microbes in adapting to stationary phase. DOI: http://dx.doi.org/10.7554/eLife.01501.001.
我们报告了在枯草芽孢杆菌中发现的一种用于生物膜形成的简单环境感应机制,该机制在没有特定RNA或蛋白质参与的情况下运行。生物膜阻遏蛋白SinR基因中的某些丝氨酸密码子,即四个TCN密码子,在生物膜诱导条件下会导致SinR水平降低。这些TCN密码子被AGC或AGT同义替换会损害生物膜形成和基因表达。相反,将AGC或AGT转换为TCN密码子会上调生物膜形成。全基因组核糖体分析表明,在生物膜形成过程中,UCN密码子处的核糖体密度高于AGC或AGU处。丝氨酸饥饿重现了生物膜诱导条件对核糖体占据率和SinR产生的影响。由于丝氨酸是指数生长期结束时最早耗尽的氨基酸之一,其他微生物可能利用丝氨酸密码子处降低的翻译速度来适应稳定期。DOI: http://dx.doi.org/10.7554/eLife.01501.001